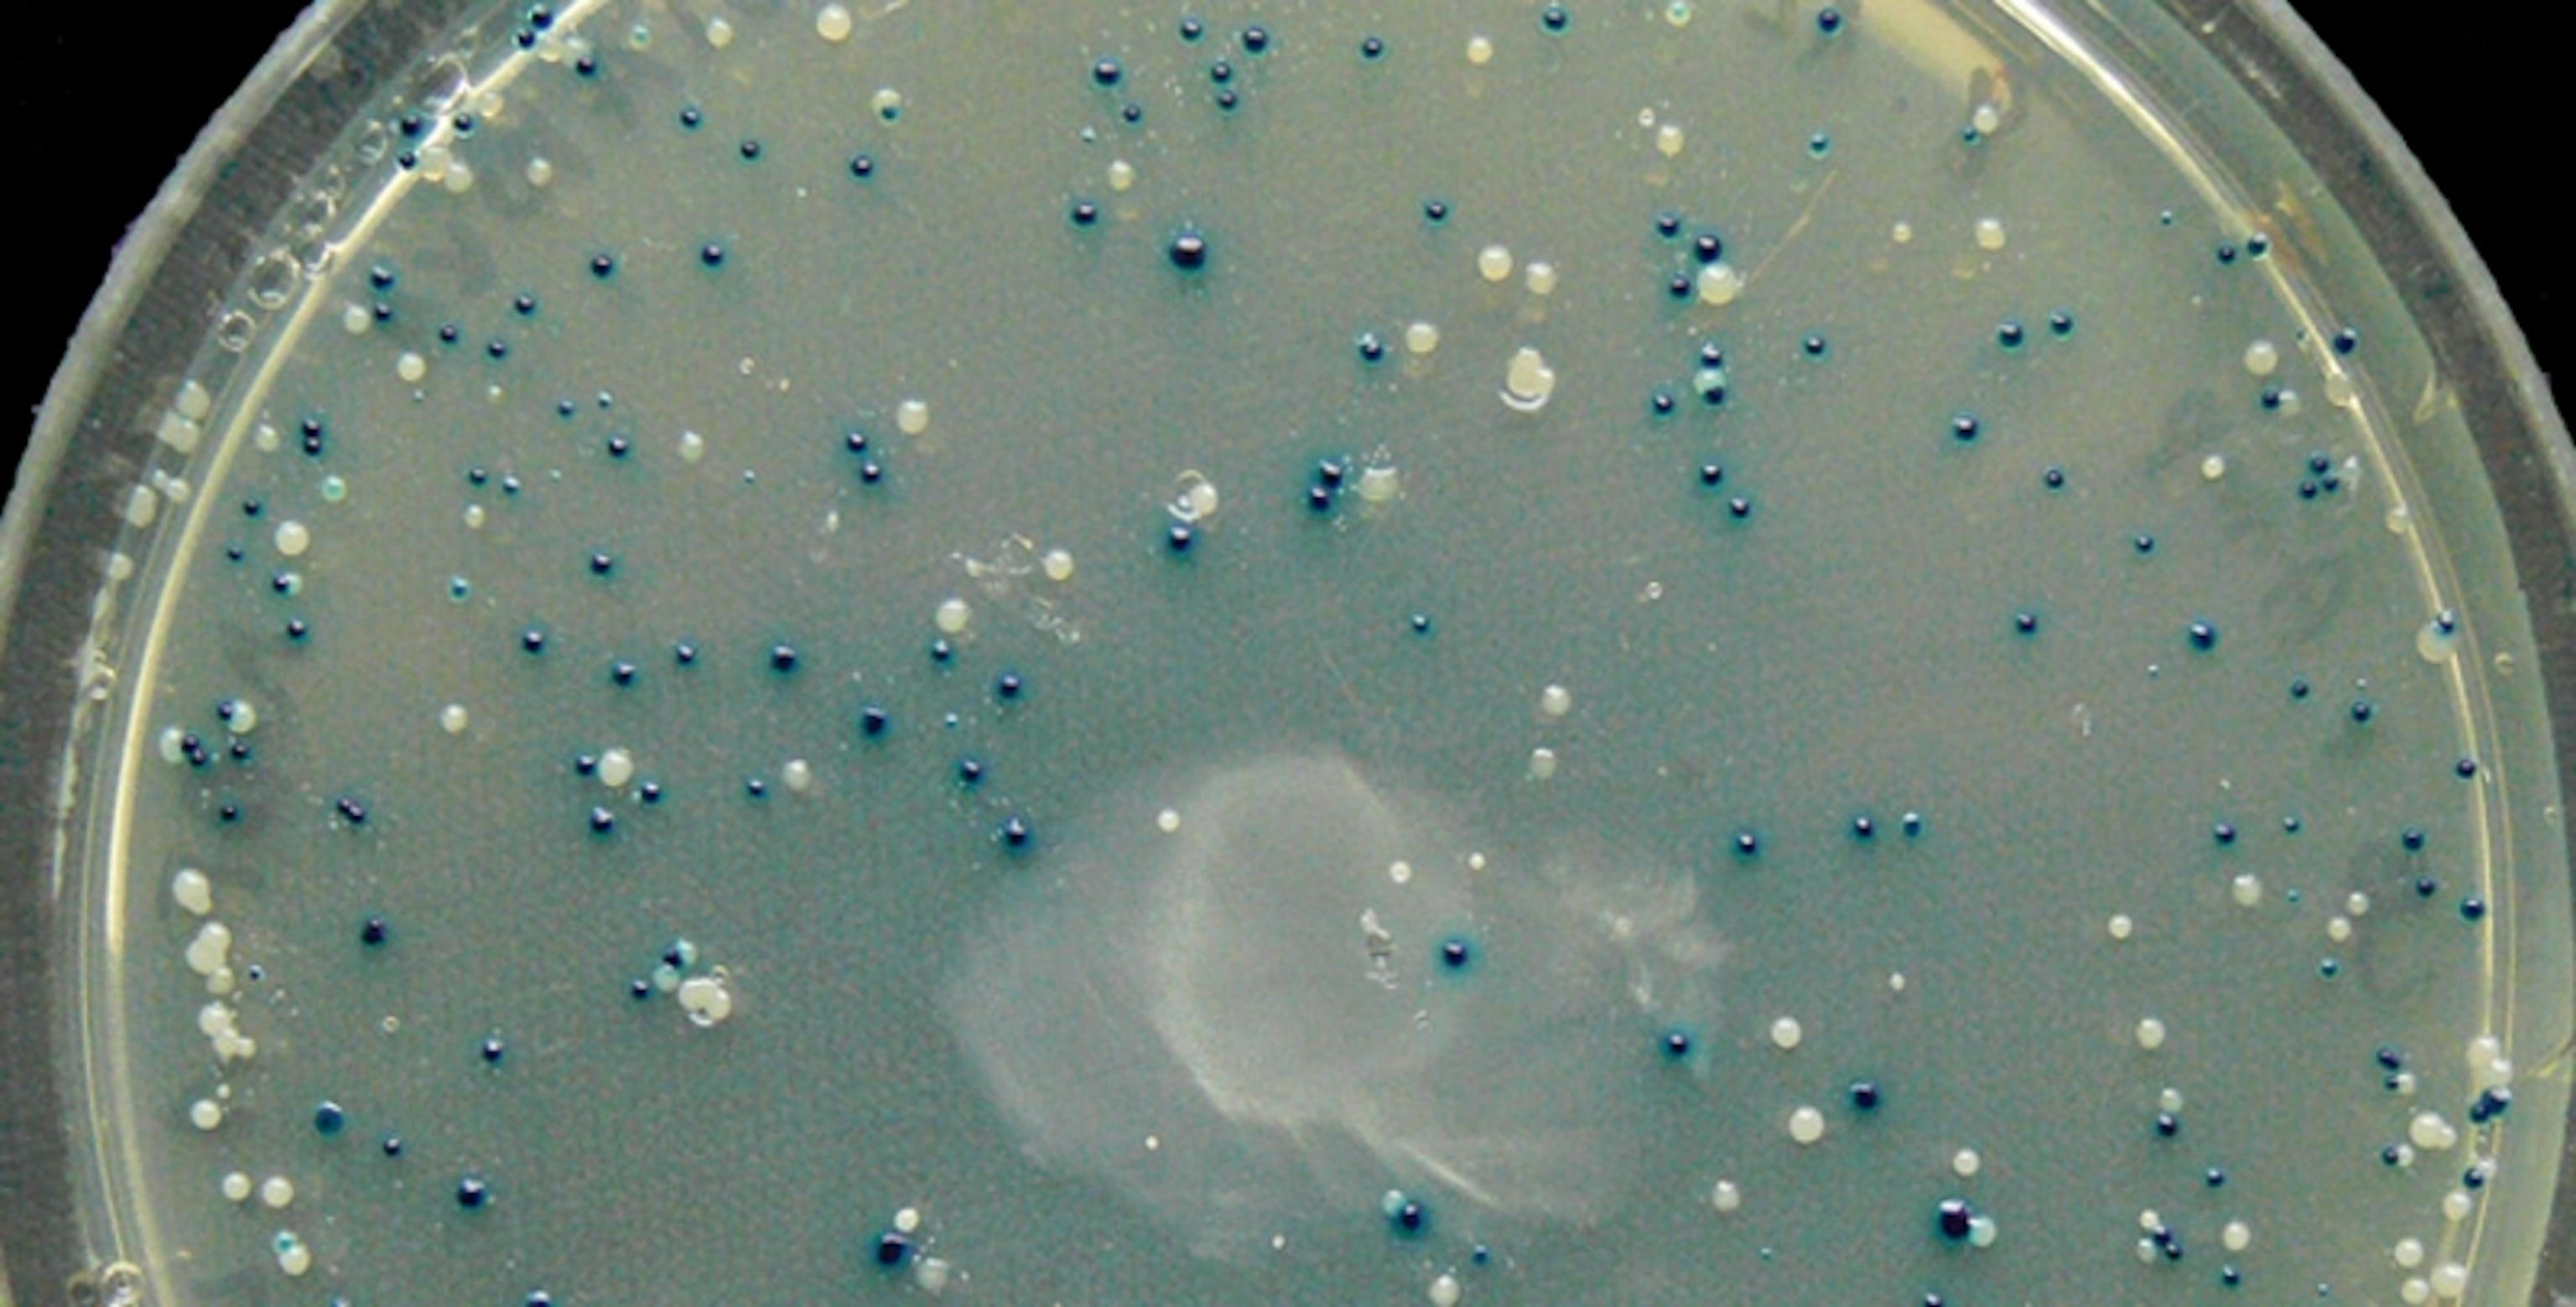

How to Turn Gut Bacteria Into Journalists
The gut is a dark and hidden world. We usually only know what’s happening within it when something goes badly wrong. But there are trillions of microbes in our guts; with their first-hand experience, they’re perfectly positioned to tell us about what’s going on inside ourselves. Pamela Silver from Harvard Medical School is now training them to do that. Her team is transforming gut bacteria into journalists—microscopic reporters who cover the bowel beat.
So far, they have loaded E.coli—a common gut microbe—with a genetic circuit that allows it to detect and remember the presence of an antibiotic. These engineered bacteria can colonise the guts of mice to no ill effect. If the mice get the antibiotic in their diet, the bacteria all flip to a different state, which the team could assess by analysing the rodents’ poo.
It’s a simple proof-of-principle, and detecting an antibiotic isn’t massively useful. But the study lays the groundwork for more exciting applications, which the team are already starting to pursue. Imagine microbial reporters that can spot the chemical signatures of inflammation, disease-causing bacteria, or environmental toxins.
The project is part of the growing field of synthetic biologygrowing field of synthetic biology. Its practitioners bring the ethos of engineering into the world of living things, by combining different genetic “parts” or “modules” to create organisms with new abilities. Many of the initial successes were cute demos, like photographic bacteria, but the field is now moving towards more serious applications, like yeast that can brew antimalarial drugs, cells that self-destruct if they turn cancerous, or bacteria that make plant roots grow longer. “We’re tired of making toy systems that don’t necessarily have an application,” says Silver.
To create her reporter bacteria, Silver teamed up with two partners—Jeffrey Way at Harvard’s Wyss Institute, and a virus called lambda. Lambda is a bacteriophage—a virus that infects bacteria. Its life cycle has two stages—one where it actively reproduces and kills its host, and another where it wheedles its way into its host’s genome and sits there, dormant and harmless.
It flips between these two states using a genetic switch involving two genes—cI and cro—which mutually block each other. If cI wins this battle and Cro is inactive, the phage opts for the dormant, hidden lifestyle. If Cro wins and cI is inactive, the phage goes for the more lethal route. Environmental influences, like hunger or radiation, can change the balance between the two genes, flipping the phage from one lifestyle to another.
The lambda switch was perfect for Silver and Way’s needs—it provided a way of changing between two states, depending on an outside signal. It also came with two huge advantages.
First, in the 1970s and 80s, scientists like Mark Ptashne unpicked exactly how switch works at the most intimate level; Silver once worked in Ptashne’s lab, and Way was in a lab next door. “We understood it in a level of detail that you can’t get from a textbook,” he says.
Second, the lambda switch never fails. A cell is a chaotic environment, and genes get switched on by accident all the time. But that would be disastrous for lambda—if it flips from dormancy to active killing at the wrong moment, it risks going down with its host. So natural selection has fashioned a switch that goes all-or-nothing in two possible directions, and is extraordinarily stable. It just doesn’t flip by accident. “I’d challenge you to find a human-designed circuit that works that well,” says Silver.
The team took the switch out of the lambda genome and implanted it into E.coli. They tweaked it so that it starts in the cI state, and stably flips to the Cro state in response to an antibiotic called tetracycline. In the Cro state, the bacteria switch on another gene that turns them blue if they’re grown in the right conditions. The upshot: if you grow these bacteria in the lab, their colour will tell you if they’ve seen tetracycline. They detect, they remember, and they report.
At first, team members Jonathan Kotula and Jordan Kerns tested this modified switch in laboratory strain of E.coli. But eventually, they showed that it also works in a wild one that actually lives in mouse guts. When they fed this strain to the mice, it established itself nicely and behaved exactly as the team wanted. Both phases are important—the team need to be able to test future genetic circuits in lab-reared microbes that won’t cause problems for natural ones, but that will eventually work in natural strains once they have been perfected.
Chris Voigt from MIT is impressed, especially because the circuit “worked so robustly in the messy gut of a mouse”. Many synthetic biologists have tried to programme cells with specific genetic circuits, and while these often work in the lab, they fail in real environments. “This is one of the few examples—if not the only one—of a circuit working out of a test tube or fermenter,” says Voigt.
Silver and Way are now hard at work on their next applications, all of which use the lambda switch at their core. Their ultimate vision is to engineer bacteria that will not only detect changes in the gut but also respond to them. Imagine a strain that detects the early signs of inflammation and makes an anti-inflammatory drug, or that sense a harmful species of microbe and makes an antibiotic. They would be journalists and doctors.
“We know it’ll work,” says Silver. “We already have some preliminary data. Once we know the fundamentals of this device, we can keep on tweaking it, putting in downstream things like therapeutics or upstream thing like sensors.”
These applications may take many years to realise; for now, the team’s work is already a testament to the value of basic science. Back in the 1970s and 1980s, none of the scientists who were studying phages would ever have guessed that their work could be used in this way.
Even Way wasn’t convinced. “There were a huge amount of picky details that seemed like they could never possibly be relevant, or weren’t necessary for demystifying life,” he says. “But those picky details have been really useful in doing this engineering. The textbook level isn’t good enough, which is why a lot of attempts at synthetic biology fail, or create non-robust systems.” Nature makes things look simple, but to emulate it, we need to understand its details.
Reference: Kotula, Kerns, Shaket, Siraj, Collins, Way & Silver. 2014. Programmable bacteria detect and record an environmental signal in the mammalian gut. PNAS http://dx.doi.org/10.1073/pnas.1321321111
More on synthetic biology: Can We Save the World by Remixing Life?